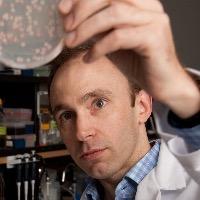

Contact details +6492136611
Prof Timothy Cooper
Professor of Molecular Biosciences
School of Natural SciencesResearch Expertise
Research Interests
Tim works on understanding the dynamics of microbial adaptation. These dynamics determine the ability of microbes to adapt and compete in both benign and stressful environments, like those presented by the use of antibiotics. His work focusses on the genetics of adaptation, especially on how interactions among genetic mutations and the environment influence evolutionary outcomes.
Area of Expertise
Field of research codes
Biological Adaptation (060303):
Biological Sciences (060000):
Evolutionary Biology (060300):
Genetics (060400):
Microbial Genetics (060503):
Microbiology (060500):
Molecular Evolution (060409)
Keywords
Evolutionary biology, Microbiology, Experimental evolution
Teaching and Supervision
Current Doctoral Supervision
Main Supervisor of:
-
Kelly Hong
-
Doctor of Philosophy
Quantifying the predictability of the emergence of antibiotic resistance in a model strain and environmental isolates of Escherichia coli.
Co-supervisor of:
-
Hema Rallapati
-
Doctor of Philosophy
The molecular mechanisms of copper homeostasis in plant-associated Pseudomonas
Completed Doctoral Supervision
Main Supervisor of:
-
2023
-
Zidong Li
-
Doctor of Philosophy
Characterisation of pseudogene-like EP400NL in chromatin remodelling and transcriptional regulation -
2023
-
Huei-Yi Lai
-
Doctor of Philosophy
The maintenance and evolution of antibiotic resistance genes in the absence of antibiotic selection
Co-supervisor of:
-
2023
-
Danielle Kok
-
Doctor of Philosophy
ABAtE: Active Bacteriophages for AFB Eradication -
2021
-
Marketa Vlkova
-
Doctor of Philosophy
Natural variation in bacterial gene regulation